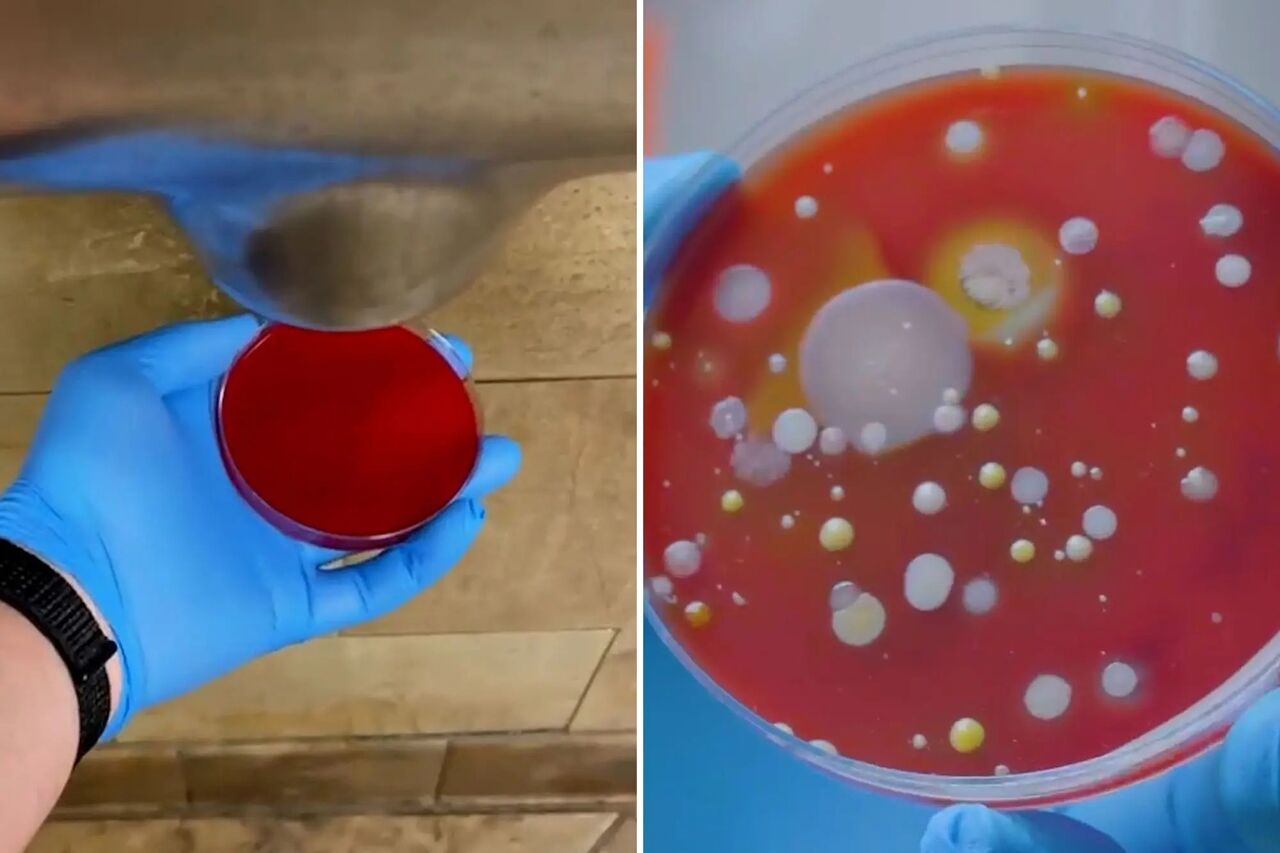
دستگاه های خشک کن دست میکروب ها را بیشتر از دستمال کاغذی پخش می کنند! (+عکس)

به گزارش سلامت نیوز به نقل از عصر ایران، طی همه گیری COVID-19، بسیاری از کسب و کارها به منظور به حداقل رساندن خطر انتشار میکروارگانیسم های آسیب رسان، به استفاده از روش های بدون نیاز به کاربرد دست و لمس روی آوردند.
به عنوان مثال، در حال حاضر بسیاری از رستوران ها به جای منوهای کاغذی سنتی از یک کد QR برای مشاهده منوی خود در گوشی هوشمند شما بهره می برند.
علاوه بر این در بسیاری از سرویس های بهداشتی عمومی نیز دستمال های کاغذی جای خود را به دستگاه های مدرن دست خشک کن داده اند. با این حال طبق یک مطالعه معتبر منتشر شده در مجله کنترل عفونت و اپیدمیولوژی بیمارستانی، مورد دوم آنقدرها هم که ما تصور می کنیم موثر نیست. در واقع دستگاه های خشک کن که با سرعت بالای حرکت هوا کار می کنند، ممکن است آلودگی بیشتری را نسبت به دستمال های کاغذی معمولی روی دست به جای بگذارند.
علاوه بر این، تکنولوژی مذکور میکروب ها را روی لباس های ما پخش می کند و منجر به تسهیل انتقال آنها به سایر سطوح می شود.
یافته های مطالعات
دکتر پوتینگر، پزشک و عضو هیئت مدیره کلینیک بیماری های عفونی و طب گرمسیری در مرکز پزشکی دانشگاه واشینگتن که البته در مطالعه جدید شرکت نداشته، توضیح می دهد: هدف از طراحی و اجرای چنین تحقیقاتی، تلاش برای درک این موضوع است که آیا روش های مختلف خشک کردن دست می توانند بر گسترش میکروب ها در محیط های عمومی و به خصوص بیمارستان ها تاثیر بگذارند یا خیر.
پوتینگر ادامه می دهد: «در این مطالعه محققان برای درک مسئله مذکور، دست های شرکت کنندگان را در معرض یک ویروس بی ضرر قرار دادند و شرایط آلودگی را از این طریق شبیه سازی کردند، سپس از شرکت کنندگان خواسته شد تا دست های خود را با استفاده از دستمال کاغذی یا خشک کن خشک کنند. آنها در ادامه میزان ویروسی که به سطوح مختلف اطراف بیمارستان منتقل شده بود را شناسایی کردند.
هنگامی که محققان این دو متد خشک کردن را با هم مقایسه کردند، مشخص شد افرادی که از دستگاه خشک کن استفاده کرده بودند نقش بیشتری در انتشار ویروس داشتند.
در پژوهشی دیگر که جزئیات آن از طریق مجله جامعه میکروبیولوژی آمریکا قابل دسترسی است، محققان برای تعیین اینکه آیا خشک کن های دست در سرویس های بهداشتی عمومی باکتری ها را روی دستان افراد پخش می کنند یا نه، مطالعه ای مستقل انجام دادند. برای بررسی این موضوع، محققان ظروف پتری را در شرایط مختلف در معرض هوای دستشویی قرار دادند و آنها را به آزمایشگاه بردند تا ببینند که آیا واقعا باکتری ها روی این ظروف رشد می کنند یا خیر.
و اما آنچه آنها دریافتند: ظروف پتری که به مدت دو دقیقه در معرض هوای دستشویی قرار گرفته بودند آن هم در حالی که خشک کن دست خاموش بود، تنها یک کلونی از باکتری ها را رشد داده بودند و حتی در یک سری از پتری ها اصلا هیچ میکروارگانیسمی رشد نکرده بود.
اما ظروف پتری که به مدت 30 ثانیه در معرض هوای گرم خشک کن دستشویی قرار گرفته بودند، مجموعا تعداد حیرت آور 254 کلنی باکتریایی را نشان دادند (اکثر آنها بین 18 تا 60 کلنی باکتری داشتند).
در نهایت بهترین راه برای شستن و خشک کردن دست ها چیست؟
پوتینگر می گوید: نکته مهم این است که دست هایمان را با دقت با آب و صابون به مدت حداقل 30 ثانیه شست و شو دهیم. وی ادامه می دهد: روشی که ما برای خشک کردن دست هایمان انتخاب می کنیم، اهمیت نسبتا کمتری دارد. اما همانطور که این مطالعه و بررسی های مشابه نشان می دهند، انتخاب دستمال کاغذی به جای خشک کن برقی می تواند با مزایای زیادی همراه باشد. در هر صورت، مهم ترین هدف این است که اطمینان حاصل کنیم که دست های تمیز خود را از تماس با سطوح آلوده از جمله دستگاه حاوی دستمال کاغذی یا خشک کن دور نگه داشته ایم.
پوتینگر می گوید که او شخصا دستمال کاغذی را انتخاب می کند، نه تنها به دلایلی که در مطالعه نشان داده شده است، بلکه به این علت که این کار به او اجازه می دهد تا دستگیره در دستشویی را با دستمال کاغذی بگیرد و از آلوده شدن مجدد دست و دستگیره جلوگیری کند.
محققان دیگر نیز با این موضوع موافق هستند که شستن صحیح دست ها مهمترین بخش این فرآیند است. در واقع مهم نیست دست هایمان را با چه چیزی خشک کنیم اگر همچنان باکتری و ویروس روی آنها وجود داشته باشد، زیرا مرحله اولیه شستن آنها را به خوبی انجام نداده ایم.
در این میان دومین انتخاب مناسب برای پاکسازی دست ها، استفاده از ضدعفونی کننده های دست با حداقل 60 درصد الکل است. با این حال، این روش به اندازه صابون، آب و روش صحیح شستشوی دست میکروب ها را از بین نمی برد.















نظر شما